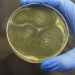

Invasive Pilze - Lena Ganschow und die neue Bedrohung
Harmlose Blumenidylle? Von wegen! Hier gedeihen gefährlichen Pilze. Um ihr Geheimnis zu lüften, muss Lena Ganschow die Blumen buchstäblich bei der Wurzel packen.
Bildauswahl:

Harmlose Blumenidylle? Von wegen! Hier gedeihen gefährlichen Pilze. Um ihr Geheimnis zu lüften, muss Lena Ganschow die Blumen buchstäblich bei der Wurzel packen.

In Kiel besucht Lena Ganschow die Wissenschaftlerin Prof. Eva Stukenbrock. Sie untersucht, wie sehr unsere Nutzpflanzen unter Pilzinfektionen leiden.

Harmlose Blumenidylle? Von wegen! Lena Ganschow besucht Forschende, die genau hier gefährlichen Pilzkulturen auf die Spur gekommen sind.
Im Labor machen sie Wissenschaftlerinnen und Wissenschaftler auf die Suche nach wirksamen Gegenmitteln gegen die gefährlichen Pilzkulturen.

Kompost ist ein Paradies für Pilze. Doch längst nicht alle darin sind harmlos.

